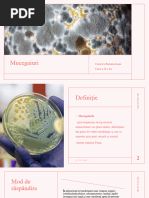

0% au considerat acest document util (0 voturi)
132 vizualizări17 paginiMotorul Otto
Documentul prezintă istoricul și funcționarea motorului cu combustie internă inventat de Nikolaus Otto în 1876, care utilizează ciclul în patru timpi. Motorul Otto a fost primul motor cu ardere internă eficientă și a rămas neschimbat ca principiu până în prezent, fiind baza tuturor motoarelor termice moderne.
Încărcat de
roxxyr777Drepturi de autor
© © All Rights Reserved
Respectăm cu strictețe drepturile privind conținutul. Dacă suspectați că acesta este conținutul dumneavoastră, reclamați-l aici.
Formate disponibile
Descărcați ca PPTX, PDF, TXT sau citiți online pe Scribd
0% au considerat acest document util (0 voturi)
132 vizualizări17 paginiMotorul Otto
Documentul prezintă istoricul și funcționarea motorului cu combustie internă inventat de Nikolaus Otto în 1876, care utilizează ciclul în patru timpi. Motorul Otto a fost primul motor cu ardere internă eficientă și a rămas neschimbat ca principiu până în prezent, fiind baza tuturor motoarelor termice moderne.
Încărcat de
roxxyr777Drepturi de autor
© © All Rights Reserved
Respectăm cu strictețe drepturile privind conținutul. Dacă suspectați că acesta este conținutul dumneavoastră, reclamați-l aici.
Formate disponibile
Descărcați ca PPTX, PDF, TXT sau citiți online pe Scribd